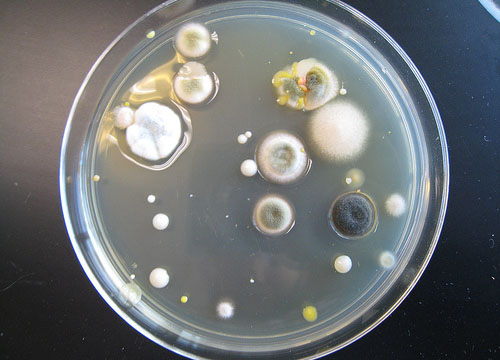

AsianScientist (Dec. 7, 2011) – An American researcher at the Smithsonian Institution says he has found the world’s biggest bug on New Zealand’s Little Barrier Island.
The insect, shown here eating a carrot, has a wing span of around 18 centimeters (7 inches) and weighs three times as much as a mouse. It was thought to be extinct after European settlers brought rats to New Zealand.
The giant weta bug was found by 53-year-old entomologist and photojournalist Mark Moffett, who has been called the Indiana Jones of Entomology by the National Geographic Society.
“Three of us walked the trails of this small island for two nights scanning the vegetation for a giant weta. We spent many hours with no luck finding any at all, before we saw her up in a tree,” he said.
However, Moffett did what a responsible explorer would do – he returned the bug right where he found it.
“She would have finished the carrot very quickly, but this is an extremely endangered species and we didn’t want to risk indigestion. After she had chewed a little I took this picture and we put her right back where we found her,” he said.
——
Source: Animal Planet; photo: Mark Moffett.
Disclaimer: This article does not necessarily reflect the views of AsianScientist or its staff.